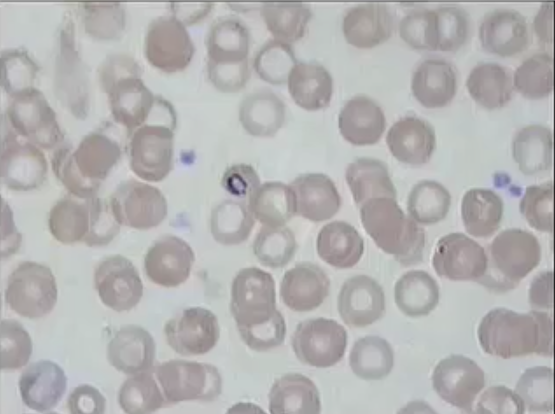
<p>Give ONE specific epithet name of this organism.</p>
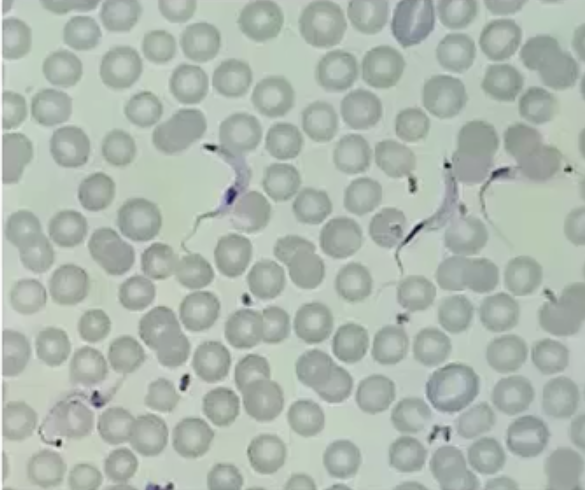
<p>What phylum and genus is being pictured here?</p>

Protista (Exam 2)
1/34
Earn XP
Description and Tags
for Microbio
Name | Mastery | Learn | Test | Matching | Spaced | Call with Kai |
|---|
No analytics yet
Send a link to your students to track their progress
35 Terms
What is the taxonomical classification of Protista?
Domain Eukarya
Kingdom Protista
What phyla exist within Kingdom Protista?
Chlorophyta, Bacillariophyta, Dinophyta, Archaeozoa, Amoebozoa, Apicomplexa, Euglenozoa, Ciliophora
What is phycology?
the study of algae
What are the two common names (NOT CLASSIFICATIONS) for organisms in Kingdom Protista?
algae and protozoa
What are the unique characteristics of algae?
cell wall, chloroplasts, photoautotrophs
What materials often come from algal cell walls?
cellulose, pectin, agar, glass

In phylum Chlorophyta, cell walls are made of _____ and ______.
cellulose, pectin
Organisms in phylum Chlorophyta are collectively called ____ and are frequently found in ______.
desmids, freshwater

Organisms in phylum Bacillariophyta have cell walls made up of _____.
glass!
Organisms in phylum Bacillariophyta are _____(environment) and are collectively called _____.
aquatic, diatoms
When diatoms die and accumulate, they form SEDIMENTARY ROCK known as “______ earth”.
diatomaceous

Organisms in phylum Dinophyta have cell walls made of ____, and are commonly called _______.
cellulose, dinoflagellates
Organisms in phylum ______ are known for being BIOLUMINESCENT.
Dinophyta

The genus name of these organisms is ____.
Ceratium
Some organisms in phylum Dinophyta produce a neurotoxin called _____, which causes paralytic shellfish poisoning. (red tide)
saxitoxin

What is the name of this event?
red tide
PROTOZOAN organisms are _____, meaning they eat whole organisms, and they are therefore __________.
holozoic, chemoheterotrophs

Organisms in phylum Archaeozoa lack ________ and therefore must live in an _____ ______,
mitochondria, animal host

What is the species name? What phylum?
Giardia lamblia, Archaeozoa

What is this FORM called?
trophozoite (active metabolizing)

What is this FORM called?
cyst (dormant form)
What animal is a reservoir for Giardia?
beaver

What is the name of this organism, and which phylum does it belong to?
Truchonmonas vaginalis, Archaeozoa

What is the name of this organism? What phylum does it belong to?
Amoeba proteus, Amoebozoa

What structure does this organism use for movement?
Pseudopodia

What is the organism within the central red blood cell? What phylum does it belong to?
Plasmodium, Apicomplexa

This organism is the causative agent of ______, and its vector is ______(genus) mosquitos.
malaria, Anopheles
Give ONE specific epithet name of this organism.
Ex: Plasmodium falciparum, Plasmodium malariae, Plasmodium vivax, Plasmodium ovale
Malaria is an _____ disease to >100 nations, meaning these nations have a constant rate of the population infected with the disease.
endemic
What is the key sign of malaria
recurring cycles (~48 hrs) of fever, chills, sweating, exhaustion. May cease or progress depending on species of Plasmodium
Plasmodium continually completes ____ reproduction in our red blood cells, causing them to ____ which results in a recurring fever.
asexual, lyse
What phylum and genus is being pictured here?
Euglenozoa, Trypanosoma
Chaga’s Disease is caused by ____ _____, and its biological vector is the “_____ ___”.
Trypanosoma cruzi, kissing bug
African Sleeping Sickness is caused by _____ ____, and its biological vector is the “___ ___ ___”.
Trypanosoma brucei, tse tse fly

What phylum and species is this?
Ciliophora, Paramecium caudatum